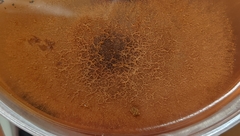
Paecilomyces

Paecilomyces: taxon details and analytics
- Domain
- Kingdom
- Fungi
- Phylum
- Ascomycota
- Class
- Eurotiomycetes
- Order
- Eurotiales
- Family
- Thermoascaceae
- Genus
- Paecilomyces
- Species
- Scientific Name
- Paecilomyces
Summary description from Wikipedia:
Paecilomyces
Paecilomyces is a genus of fungi. A number of species in this genus are plant pathogens.
Several of the entomopathogenic species, such as "Paecilomyces fumosoroseus" have now been placed in the genus Isaria, in the order Hypocreales and family Cordycipitaceae.
In 1974, R.A. Samson transferred the nematicidal species Paecilomyces lilacinus to this genus. However, publications in the 2000s (decade) indicated that the genus Paecilomyces was not monophyletic, and the new genus Purpureocillium was created to hold the taxon which includes P. lilacinum: with both parts of the name referring to the purple conidia produced by the fungus.
...Paecilomyces in languages:
- Czech
- pecilomyces